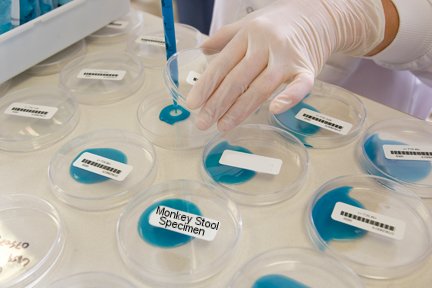

Welcome back everyone. It’s time for Tell it Tuesday my Non Advice Column. Remember I am less qualified than Lucy from Peanuts or a Magic 8 ball so if your problem is real, you probably don’t want your answer from me. But send them in anyway to beingpeachy@gmail.com after all I am ranked in Google for “epic asshattedness” .
and away we go….
***************************************
To The Peachy 1,
I am in college and my doormates have spent an entire year eating and drinking all my food supplies. Also they use my toilet paper and shampoo. I have to work to buy my things, but they are there with the finances of their parents. I don’t want to seem like a jerk but how can I prevent this from happening this year.
BMC ( Big Mooches on Campus)
Dear -BMC; Might I suggest you take to licking everything you own and taping a picture of it each item. I remember when I was a kid if you licked something it was TOTALLY yours. If this doesn’t deter your dorm mates then you will need to escalate the condition to Code Yellow. Put everything in containers. Then label everything with clever titles. ” Monkey Stool Specimen 5/13/2009″, or “Stage 5 Herpes study 6/1/2008″ Talk frequently of your cold sores and ask curiously over and over if anyone else has painful sores around their junk. Pretend to take science based classes and when you put away your groceries explain these are part of a research study you are doing to cure sexually transmitted issues. Also same theme with toilet paper. Print out a fake pie chart ( cause those are pretty) and some fake statistics. BIG HEADER – saying something like- ” Conclusive Proof of transfer of STD by Toilet Paper” tape that paper to the pack. Draw a HUGE red X with a sharpie on each roll with a date and label it study 1 and study 3. Whenever you get out a new roll use rubber gloves and make a big deal over it. Like , “OMG, I think there is a whole in my GLOVE, shit, you guys I’ll be right back I have to contact the professor and the CDC. This should help slow them down a little when they are sober. Good luck ThePeachy1
********************************
Dear Peachy1:
I live next door to June Cleaver. This hag is working my last nerve. She has some type of cooking, jewelry, candle, art or even gold party every week ! I am always invited but after the first 50 or so I am worn out. I don’t want to spend any more money buying any useless crap. I also don’t want the weekly bread/muffin/pie or cake she pushes off on my family that makes me feel I need to make something for her. When she returns my dish she includes “her” recipe for whatever I made. I don’t want to play her game anymore. Help.
signed,
Don’t Want to Keep Up with the Jones
Dear- Don’t Want to Keep Up with the Jones: Uhm if you don’t want all the stuff she is baking you every week you can mail it to me.. Or you could start an on-line store and sell the stuff she brings every week, then use that money to go to 1 of her parties each month? Let me know if you want my shipping address. Good luck ThePeachy1
Dear The Peachy 1:
I have been dating this guy that I really like. We have been going out about 7 weeks and haven’t slept together. I am ready to “go there”. See he thinks I am nice girl since we waited. So when we finally hit the sack, should I pull out all my tricks or play it safe because I don’t want to scare him away because I think he could be the one.
Wild & Wanting
Dear- Wild & Waiting, Wow, this is a great debate. You said he thinks your a good girl, does this mean your not and your faking it? I would say have fun, enjoy the “hooking up” with the guy who could be ” the one”. Don’t play stupid but I would break out the trapeze, whip and ball gag on the first go around. You know him better than me. But most of my guy friends say they want a lady during the day and a wild woman in the bed. It sounds like you might just be right for that job. Good Luck I want to know how this turns out. ThePeachy1
So that brings this weeks Tell it Tuesday to a close. Remember I am not qualified in any manner to give anyone advice about anything so please keep your awesome questions coming.
PEACH OUT………..

If I had June Clever as a neighbor, I would sleep with her husband, video tape it and release on YouTube, or report her to homeland security for “suspicious activity” then sit back and watch as they bust her door down.
I thought about telling her to constantly hit on her neighbors husband but then it could open a can of nasty worms cause they could be all freaky or something…
I had a friend who got annoyed with his dorm-mates constantly “borrowing” his milk when he was at University. His solution was a bottle of milk spiked with powerful laxatives, combined with going around all the toilets in the dorm and removing all the toilet paper…
Apparently the “borrowing” stopped after this:-)
yep that sounds like it would send a powerful message.
ok…whats a sex trick…
Jeff. There are lots of sex tricks.. Tons, books even written on them. Each girl has their own that they have picked up from other girls or boyfriends along the way. Thus making a sex trick treasure chest if you will. The young lady in this question asked if she should pull out all the “tricks” on her first time with the new guy. I don’t know what her particular tricks are, however, I suggested she might want to keep some of them ” in the chest” for a later date as to not scare the crap out of him.